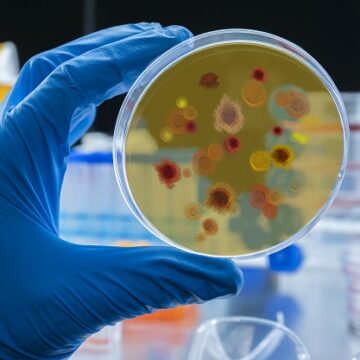

El Fondo Mundial está introduciendo varias medidas de adaptación para el Ciclo de Subvenciones 7 (GC7) y el resto del Ciclo de Subvenciones 6 (GC6) que buscan garantizar la continuidad de la programación esencial, aplazando la inversión en algunas áreas y animando la repriorización de las actividades. Es posible que las subvenciones deban priorizar suministros...
Category: Uncategorized
Informe Semestral de Progreso – Agosto 2024
Asunto: Informe Semestral de progreso sobre las acciones principales como Miembro de la Junta y Miembro Alterno de la Junta Directiva del Fondo Mundial de lucha contra el SIDA, el Paludismo y la Tuberculosis en representación de la Constituyente de Latinoamérica y el Caribe (LAC). Honorables Autoridades de los Ministerios y Secretarías de Salud, Con...
Soberanía Sanitaria en la Innovación y desarrollo de tecnologías médicas para responder a emergencias de Salud Pública
Los días 29 y 30 de julio de 2024, diversas organizaciones se dieron cita en Río de Janeiro para examinar la situación de los países del Sur Global en términos de lecciones aprendidas de la respuesta a la pandemia de covid y la capacidad de preparación y respuesta rápida y resiliente a la Emergencia de...
Estrategias mundiales del sector de la salud contra el VIH, las hepatitis víricas y las infecciones de transmisión sexual para el periodo 2022-2030
Las estrategias mundiales del sector de la salud para 2022-2030 contra el VIH, las hepatitis víricas y las infecciones de transmisión sexual tienen como objetivo orientar al sector de la salud a la hora de aplicar respuestas estratégicas destinadas a alcanzar los objetivos de poner fin al sida, las hepatitis víricas B y C y...
Fondo de pandemias y riesgos se discuten en reunión del Comité de Auditoría y Finanzas
El Comité de Auditoría y Finanzas (AFC) llevó a cabo su 21ra Reunión el 15 y 16 de marzo de 2023 de manera presencial en Ginebra, Suiza, seguida de una reunión virtual el 30 de marzo; y emitió un resumen sobre los temas abordados: Informe de Desempeño estratégico a fin del año 2022 y Actualización...
Mosquiteros tratados con insecticidas duales para responder a la malaria
14 de marzo de 2023 GINEBRA – El Fondo Mundial de Lucha contra el SIDA, la Tuberculosis y la Malaria y Unitaid dan la bienvenida a la recomendación de la OMS para el uso generalizado de una nueva clase de mosquitero que utiliza dos ingredientes activos: piretroide y clorfenapir. El nuevo mosquitero ha demostrado aproximadamente...
Venezuela es eligible para el financiamiento del Fondo Mundial
En una decisión electrónica, el 16 de agosto, la Junta de Gobierno del Fondo Mundial aprobó la elegibilidad de Venezuela para el periodo de asignación de recursos 2023 – 2025 para los componentes de malaria y tuberculosis, sobre la base de las recomendaciones del Comité de Estrategia que se describieron en el documento de propuesta...
El Fondo Mundial se reunió para preparar la Séptima Reposición de recursos
El pasado 23 y 24 de febrero se llevó a cabo la reunión preparatoria para la Séptima Reposición del Fondo Mundial. Durante la misma se presentaron los argumentos a favor de la inversión para continuar la lucha contra el VIH y el sida, la tuberculosis y la malaria. Participaron de la misma el Director Ejecutivo...
Anuncian el desarrollo de primera vacuna contra el paludismo
El pasado 26 de julio de 2021, la iniciativa de la asociación para Hacer Retroceder a la Malaria (Roll Back Malaria) anunció el proyecto de kENUP Foundation y BioNTech para desarrollar la primera vacuna para profilaxis del paludismo con base en mRNA. El proyecto apunta al uso de la tecnología mRNA como parte de la iniciativa...
Informe semestral de progreso de la gestión de la Dra. Mirta Roses (junio 2021)
29 de mayo de 2021. Honorables Autoridades de los Ministerios y Secretarías de Salud, Con la mayor consideración, tengo el agrado de enviarles el informe de progreso sobre las acciones principales desarrolladas durante mi gestión como Miembro Alterno de la Junta Directiva del Fondo Mundial para SIDA, Paludismo y Tuberculosis, en representación de la Región...